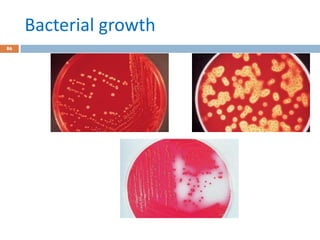
Bacterial growth
86
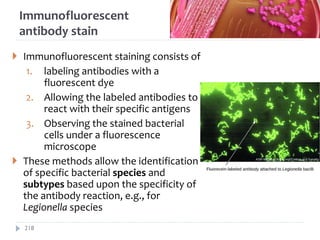
Immunofluorescent
antibody stain
 Immunofluorescent staining consists of
1. labeling antibodies with a
fluorescent dye
2. Allowing the labeled antibodies to
react with their specific antigens
3. Observing the stained bacterial
cells under a fluorescence
microscope
 These methods allow the identification
of specific bacterial species and
subtypes based upon the specificity of
the antibody reaction, e.g., for
Legionella species
218
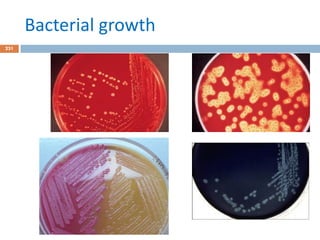
Bacterial growth
231

The document outlines the course content for a medical microbiology program by Dr. Alem A., covering various chapters on general microbiology, systematic bacteriology, virology, mycology, and microbial infections. It describes the assessment methods, the relevance of microbiology in understanding different microorganisms, and the historical development of microbiology, including contributions from key figures like Louis Pasteur and Robert Koch. The course emphasizes the structure, classification, and pathogenicity of various microbes, including bacteria, fungi, and viruses.

![Fungal classification…
c. Dimorphic fungi
• exhibit thermal dimorphism (i.e., exist as yeast
at body temperature [37°C] and mould at room
temperature [25°C])
• Example
o Histoplasma capsulatum
o Blastomyces dermatitidis
o Coccidioides immitis
o Paracoccidioides brasiliensis
14
8](https://image.slidesharecdn.com/generalmicrobiology-amc-2024complete-250123142224-1949f010/85/General-Microbiology-AMC-2024_Complete-p-148-320.jpg)